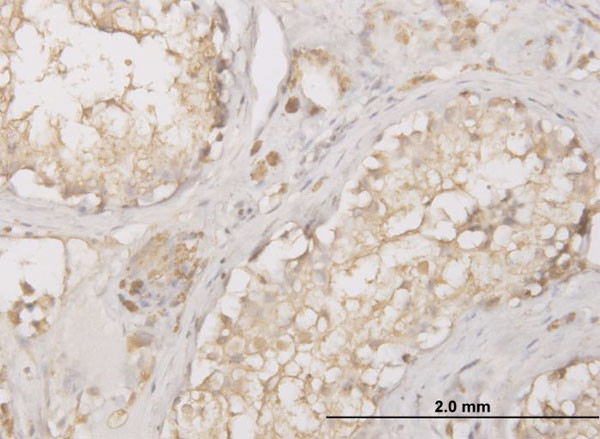
CTSD Antibody in Immunohistochemistry (Paraffin) (IHC (P))

Search
Abnova
CTSD Monoclonal Antibody (3F12-1B9)
{{$productOrderCtrl.translations['antibody.pdp.commerceCard.promotion.promotions']}}
{{$productOrderCtrl.translations['antibody.pdp.commerceCard.promotion.viewpromo']}}
{{$productOrderCtrl.translations['antibody.pdp.commerceCard.promotion.promocode']}}: {{promo.promoCode}} {{promo.promoTitle}} {{promo.promoDescription}}. {{$productOrderCtrl.translations['antibody.pdp.commerceCard.promotion.learnmore']}}
产品信息
H00001509-M01
宿主/亚型
分类
类型
克隆号
抗原
偶联物
形式
浓度
规格
保存条件
运输条件
产品详细信息
Sequence of this protein is as follows: LHKFTSIRRT MSEVGGSVED LIAKGPVSKY SQAVPAVTEG PIPEVLKNYM DAQYYGEIGI GTPPQCFTVV FDTGSSNLWV PSIHCKLLDI ACWIHHKYNS DKSSTYVKNG TSFDIHYGSG SLSGYLSQDT VSVPCQSASS ASALGGVKVE RQVFGEATKQ PGITFIAAKF DGILGMAYPR ISVNNVLPVF DNLMQQKLVD QNIFSFYLSR DPDAQPGGEL MLGGTDSKYY KGSLSYLNVT RKAYWQVHLD QVEVASGLTL CKEGCEAIVD TGTSLMVGPV DEVRELQKAI GAVPLIQGEY MIPCEKVSTL PAITLKLGGK GYKLSPEDYT LKVSQAGKTL CLSGFMGMDI PPPSGPLWIL GDVFIGRYYT VFDRDNNRVG FAEAARL
靶标信息
Cathepsin D is a gene located on chromosome 11p15.5 that encodes a lysosomal aspartic protease involved in the degradation of proteins. This enzyme is widely expressed in various tissues but is particularly abundant in the liver, kidneys, and brain, where it plays a crucial role in intracellular protein catabolism and turnover. Cathepsin D is synthesized as an inactive precursor, procathepsin D, which is activated in the acidic environment of lysosomes. Beyond its fundamental role in protein degradation, Cathepsin D has been implicated in several physiological and pathological processes, including apoptosis, hormone processing, and antigen presentation. Dysregulation of Cathepsin D expression or activity is associated with various diseases, such as neurodegenerative disorders, cancer, and cardiovascular diseases. In the context of cancer, Cathepsin D overexpression has been linked to tumor progression and metastasis, making it a potential biomarker and therapeutic target. Research continues to explore its diverse biological functions and therapeutic implications in various medical conditions.
仅用于科研。不用于诊断过程。未经明确授权不得转售。